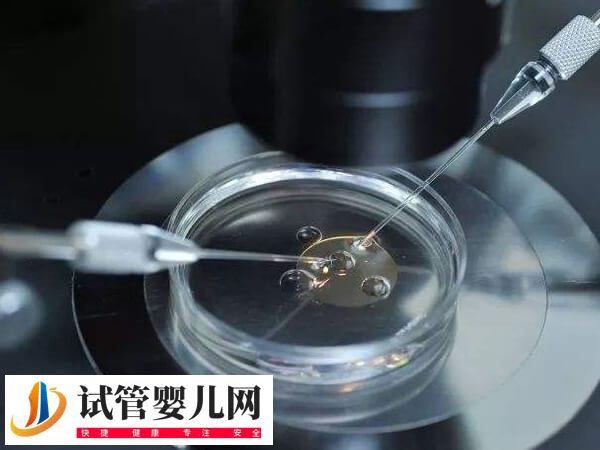
怀双胞胎有没有可能是两次同房(图1)

双胞胎的形成与多个因素有关,包括激素水平、遗传因素、促排卵药物使用等,但怀双胞胎的可能性与同房的次数并没有直接关系。因此,能否怀上双胞胎更多地取决于受精卵的分裂和发育情况,而不是性生活的频率。建议患者也无需过于追求双胞胎,毕竟双胎妊娠存在一定的妊娠风险。
怀双胞胎与同房次数无关系
双胞胎可以分为同卵双胞胎和异卵双胞胎两种类型。同卵双胞胎是由一个受精卵分裂而成的,而异卵双胞胎则是由两个不同的卵子分别被两个不同的精子受精形成的。所以从理论上来说,两次同房并不直接影响双胞胎的形成。
此外,怀上双胞胎的可能性受到多种因素的影响,包括遗传、生理状况及辅助生殖技术等。不过还需要注意的是,怀双胞胎虽然令人兴奋,但也会增加母体和胎儿的健康风险。因此,在任何尝试之前,建议咨询医生并进行全面的医疗评估。
如何备孕才能生双胞胎
1、高龄备孕
同卵双胞胎是由一个受精卵分裂成两个独立胚胎而成,这种情况较为罕见,且与遗传、年龄等因素关系不大。而异卵双胞胎则是由两个不同的卵子同时受精形成,这种情况更可能受到一些外界因素的影响。
2、家族遗传
如果家族中有双胞胎的先例,尤其是父母或兄弟姐妹中有人是双胞胎,那么怀上双胞胎的几率就会相对较高。比如妈妈的家族中有过生双胞胎的,这样的女性怀上双胞胎的几率就会显著增加,几率高达1.7%。

3、促排卵药物
理论上,女性每月有一个优势卵泡成熟,如果怀孕,就是单胎。使用促排的药物,每月可以使多个卵泡成熟,这样就可以使多个卵子有机会被受精,进而形成双胞胎。
4、辅助生殖技术
针对存在不孕症患者来说,可通过辅助生殖技术如体外受精(IVF)和胚胎移植,这样医生可以选择性地移植多个受精卵到母体子宫内,从而增加双胞胎的可能性。






